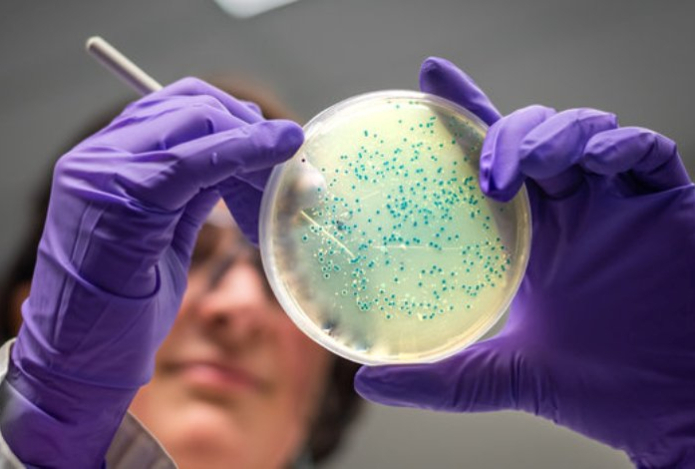

В мире зарегистрировали новый смертельный вирус
27 июля 2024, 18:50
В Бразилии зарегистрировали первую в мире смерть от вируса Оропуш, передает Sports.kz со ссылкой на «СЭ».
Это тропическая вирусная инфекция, которая распространяется мухами и комарами. Таким образом, в мире появилась новая болезнь с летальным исходом, пишет The Straits Times.
Согласно заявлениям министерства здравоохранения Бразилии, в стране от вируса умерли две женщины. Они «были младше 30 лет, без сопутствующих заболеваний, но с признаками и симптомами, похожими на тяжелый случай лихорадки денге».
Издание отмечает, что до этого в мировой медицине не фиксировались случаи смерти от вируса Оропуш. Однако в этом году в 20 штатах Бразилии уже зарегистрировали более 7,2 тысячи случаев заражения инфекцией.
Подписывайтесь на главные новости
казахстанского спорта в Telegram
Бляшки растворятся без статинов. Врач назвал продукт для выведения холестерина — подавит атеросклероз на корню
22 ноября 2024, 14:36Здоровье
Врач назвал самые опасные продукты — вызывают атеросклероз и ишемическую болезнь. Даже 100 граммов сокращают жизнь
22 ноября 2024, 13:55Здоровье
Содержит природный статин. Назван доступный продукт от холестерина — бляшки в сосудах не накопятся и к старости
22 ноября 2024, 12:49Здоровье
«Золото» на кухне. Этот жидкий продукт предотвратит артрит и диабет — хватит всего 15 граммов в день
22 ноября 2024, 11:17Здоровье


«Барыс» — «Амур»: прямая трансляция матча в КХЛ

Казахстан собрал звездный состав мужской сборной на чемпионат Азии по боксу

«Я не хочу». Аким отказался выделять средства на клуб для борьбы за «золото» КПЛ
